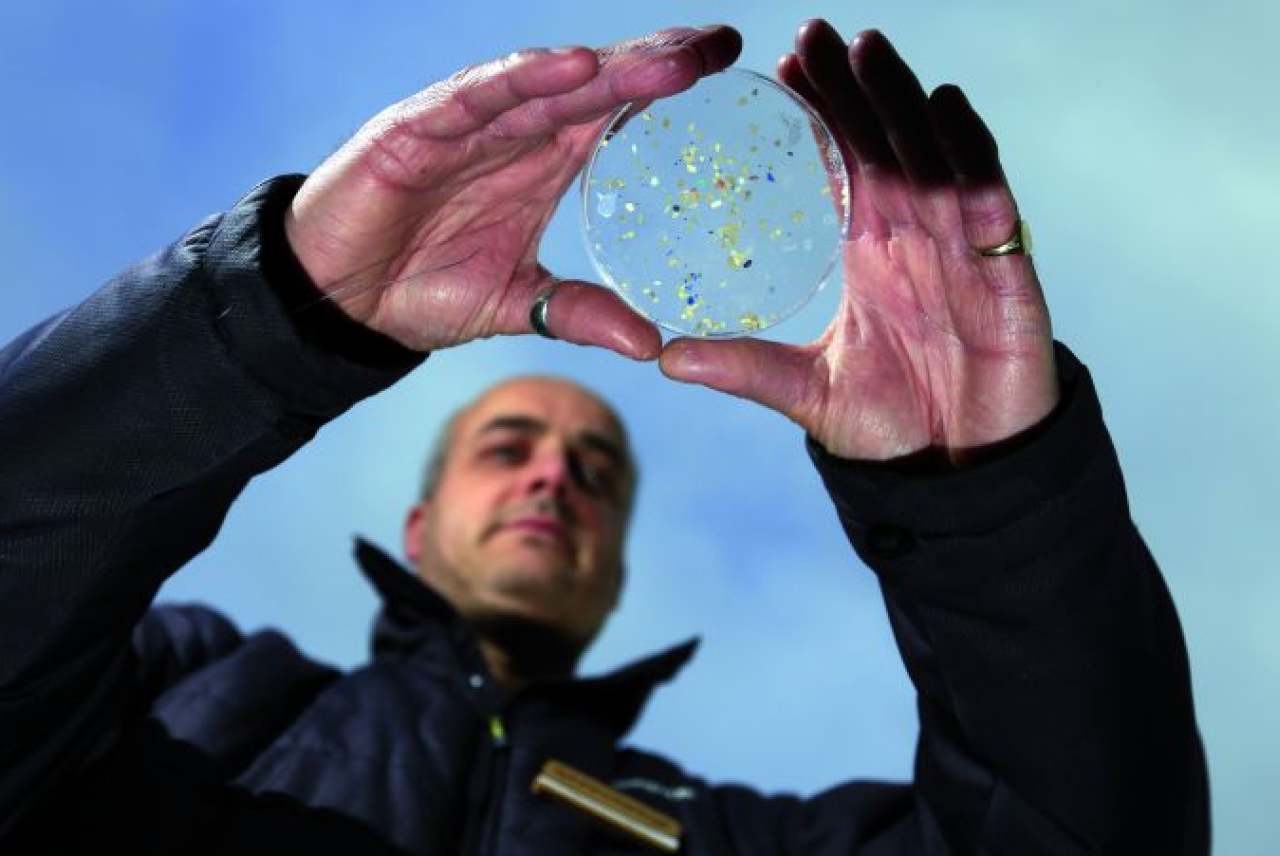

Microplastics, or microbeads, are all around us, in the air, in the water and in our soil. Recently, researchers found that the London air is especially polluted with microplastics: more particles are raining down on its citizens than in any other city in the world.
On a global average, a human being absorbs up to five grams of plastic per week, which is roughly the weight of a credit card. In Germany alone, around 1,000 tons of solid microplastic particles and almost 50 times more liquid polymers are released each year from the contents of our cosmetics and detergents into the wastewater and soil.
Codecheck’s Microplastics and Polymer Report from 2020 took a closer look at more than 50,700 personal care products and found that microplastics are prevalent in cosmetics products, posing a risk to the environment and for our health.
Invisible microplastic particles and other poorly biodegradable synthetic polymers make eyelashes more intense, foundation stay on the skin for longer and lipsticks become ‘kiss-proof’.